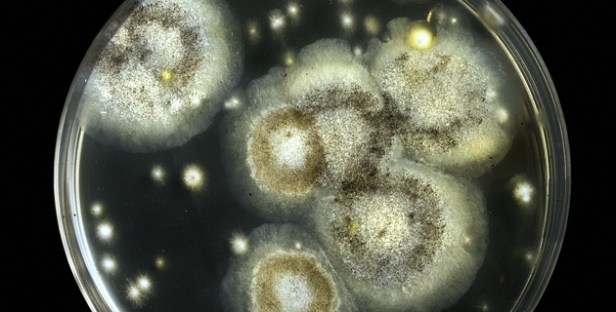
shutterstock_128453189

Ejemplo de una placa de Petri con muestras de levadura, en una vista microscópica.
Ejemplo de una placa de Petri con muestras de levadura, en una vista microscópica.
El hecho es considerado un gran hallazgo dentro de la biología sintética.
washington. Un equipo de científicos internacionales ha creado el primer “cromosoma de diseño” a partir de levadura, lo que supone un avance fundamental en el área de la biología sintética, según un estudio publicado hoy en la revista Science.
Los investigadores, liderados por Jef Boeke, del Langone Medical Center de la Universidad de Nueva York, generaron la primera copia artificial de un cromosoma de levadura.
En una investigación que ha contado con los esfuerzos de científicos en EEUU y Europa, y que se ha prolongado durante más de siete años, los científicos lograron cortar, dividir y manipular el ADN de la levadura utilizada para hacer cerveza hasta conseguir el primer cromosoma fabricado íntegramente en un laboratorio.
Boeke comenzó la investigación en la Universidad
Johns Hopkins, de Baltimore, y contó con la colaboración de sus estudiantes para llevar a cabo la titánica tarea de unir los casi 300.000 pares de cromosoma base.
Los científicos comenzaron con los fragmentos disponibles de ADN y los fueron añadiendo a otros mayores, y los agregaron luego a células de levadura, de manera que finalmente consiguieron producir una versión totalmente artificial del cromosoma.
Aunque se había logrado ya construir cromosomas de bacterias y virus, esta es la primera vez que se crea un cromosoma para un organismo eucariótico, que son más complejos (están compuestos por células con núcleos diferenciados y citoplasma organizado). Efe

